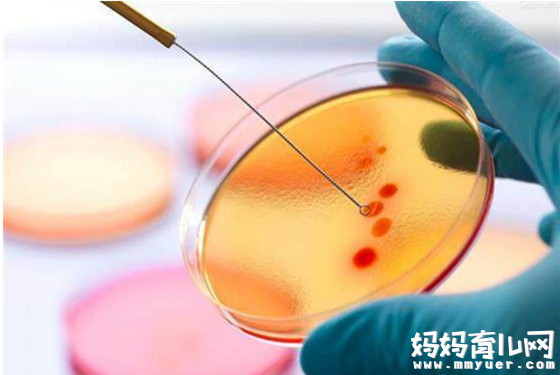

试管婴儿它是帮助那些自然受孕受阻,有生育困难的家庭圆梦的一种方式。试管婴儿运用先进的医学方式,来实现育人、造人的目的。随着科技的进步,试管婴儿也由最初的一代升级为三代了。
那么,试管婴儿是如何收费的呢?事实上,影响试管婴儿费用的因素有很多,比如:年龄不同收费不同,不孕不育的原因影响收费,医院具体的收费不同等因素的影响。
如果你也对试管婴儿的相关知识感兴趣,不防跟随本文一起来学习,试管婴儿的具体流程,影响试管婴儿的不同因素有哪些,及2017年第三代试管婴儿多少钱 第三代试管婴儿费用。

2017年第三代试管婴儿多少钱
2017年第三代试管婴儿多少钱
不孕不育专家介绍说:一次试管婴儿费用大概在8000-12000左右,费用随地方及医院的不同而有所浮动。其费用包括夫妇双方的检查、排卵的监测、人工授精的操作等费用。有的甚至包括精液的洗涤及促排卵等费用。
试管婴儿越早成功,花费越少,但是由于其成功率较低,因此患者应当有治疗几疗程而不成功的精神及经济准备,尤其在男方精液异常时。具体的费用和准备还是咨询您所就医的医院为好。
试管婴儿费用与下列因素有关:
(1)年龄不同收费不同:这一点主要是因为不同年龄的女性做试管婴儿的用药量不同,因为在生活中,女性的卵巢功能是随着大家年龄的增长而逐渐衰减的,所以在做试管婴儿的时候,年纪大的女性用药量就会多,增加了治疗费用。
(2)不孕不育原因影响收费:大家不孕不育的原因越是单纯,那么做试管婴儿的花费就越少,否则的话还需要花费额外的费用治疗会对试管婴儿有所影响的疾病。
(3)医院不同收费不同:对于不孕不育患者来说,不同的地区不同的医院有不同的收费标准。
试管婴儿具体流程:
第一阶段:检查
1.女方检查:
激素六项:卵泡刺激素(FSH)、黄体生成激素(LH)这两项在月经来潮第2-4天去医院检查。
孕酮(又称黄体素Progesterone),本项目在黄体中期或月经第21天抽。
促乳素(Prolactin)、雌二醇(E2)、睾酮(Testosterone)
基础窦卵泡数:抗苗勒激素(AMH)
2017年第三代试管婴儿多少钱
阴道超声波检查(子宫及附件)
体检项目:乙肝病毒表面抗原 HbsAg、乙肝病毒表面抗体 AntiHBs、丙肝 Anti HCV、艾滋病毒 AntiHIV、梅毒 VDRL、血常规 CBB
血糖耐受试验:空腹8小时后,早上10点前抽:血糖和胰岛素;服用75克糖水两小时后抽:血糖和胰岛素。
2.男方检查:
乙肝病毒表面抗原 HbsAg、乙肝病毒表面抗体 AntiHBs、丙肝 Anti HCV、艾滋病毒 AntiHIV、梅毒 VDRL、血常规 CBB
男方精液检查(禁欲5-7天后检查)
第二阶段:促排卵
检查完后,医生会根据检查结果制定试管方案,然后开始促排卵疗程。部分人需要降调(一般在台湾、美国等地做试管是不需要降调的,这里就不赘述),促排卵一般有以下几个方案:
1.短方案:适合年龄偏大,卵巢功能差的女士,一般需要11-17天;
2.拮抗剂方案:适合多囊卵巢综合征、卵巢功能低下、前次促排反应不良等患者,一般需要12-16天,此方案药物较贵,适用范围广,国外大多数医院首选该方案。
3.长方案:适合年龄小于40岁,基础FSH<10mIU/ml、AHM值>8的患者,一般需要25-30天。
4.超长方案:适用于子宫内膜异位、多囊卵巢、高LH血症患者,耗时51-70天左右。

2017年第三代试管婴儿多少钱
第三阶段:取卵取精、受精
促排卵完成后,医师会通知何时去取卵,取卵的时候,男方也可以取精。双方都取完后就体外受精。
第四阶段:胚胎培养、冻胚
体外受精后,胚胎会培养3-5天,一代二代试管会进行鲜胚移植。三代试管会将胚胎冻存起来,进行植入前筛查PGS/PGD,冻存时长30天左右。
第五阶段:移植
鲜胚移植在受精3-5天,冻胚移植可根据患者身体情况进行调理,在合适的时机移植即可。
第六阶段:验孕、保胎
移植后,卧趟48小时可下床活动,12天左右可以用试纸验孕。若着床成功,则保胎。若不成功,休息1个月后,可进行第二次移植。
小编的话:随着现代医学科技的发达,之前不能实现天伦之乐的家庭可以采取试管婴儿的方式来进行生育。以是的2017年第三代试管婴儿多少钱 第三代试管婴儿费用,供大家作为参考,需要提醒的是,因为各种医院的收费标准具体不统一,而且决定它的因素有所不同,所以,就存在着一些大体上的区别。
| 点赞 | 没用 | 路过 |












正在加载中... 






